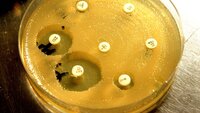
Bildet viser antibiotikaresistente bakterier i en petriskål

NTB
Innlegg av NTB:
Folsyrevitamintilskudd i svangerskapet kan forhindre forsinket språkutvikling
Tilskudd av folsyrevitamin for gravide med epilepsi kan forhindre forsinket språkutvikling hos barn forårsaket av epilepsimedisiner, viser en ny norsk studie.
Bosted kan påvirke risikoen for å utvikle MS
Postnummeret kan avsløre om danskene bor i et område med økt risiko for å utvikle MS. Dette viser en kartlegging fra det danske folkehelseinstituttet.
Overlege slår alarm om antibiotikaimport
Det er ikke trygt at Norge belager seg på import av antibiotika, sier overlege Dag Berild ved Ullevål sykehus. Han mener produksjonen må skje i Europa.
Tre eldre er syke etter bading i Oslofjorden
En 87-årig kvinne behandles for en vibrioinfeksjon etter at hun badet ved Bygdøy i Oslo. Tre eldre kvinner har blitt innlagt på sykehus på grunn av slik smitte.
Sykepleierutdanningen mangler nok praksisplasser
Mangelen på sykepleiere i Norge er stor. Likevel står flere tusen på venteliste for å komme inn på sykepleierutdanning på grunn av for få praksisplasser.
Lege skal ha behandlet kreftpasient med gurkemeie og aprikoskjerner
En privatpraktiserende lege har fått en advarsel fra Statens helsetilsyn for blant annet å ha behandlet pasienter for ikke påviste diagnoser.
Nå er faren for heteslag stor
Når temperaturen øker til over 33 grader, øker faren for heteslag betraktelig. Særlig er eldre, barn og kronisk syke i faresonen.
Jente (9) utenfor livsfare etter nesten-drukning
Den ni år gamle jenta som ble reddet opp av vannet i Mo i Rana, er utenfor livsfare, opplyser Universitetssykehuset Nord-Norge torsdag.
«Mirakelpredikantene» dropper ikke markedsføring av helbredelse
Predikantene Svein-Magne Pedersen og Tom Roger Edvardsen bestrider ifølge VG at markedsføringen av deres forbønnsmetoder er ulovlig.
Leger får beholde autorisasjonen etter bombespøk
To kvinnelige fastleger i Rogaland får ikke tilbakekalt autorisasjonen etter å ha maskert seg og tøyset med kolleger gjennom å kaste fra seg en ryggsekk.